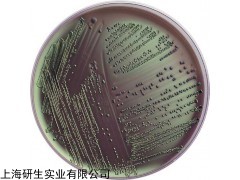

| 提交询价信息 |
| 发布紧急求购 |

价格:电议
所在地:上海
型号:
更新时间:2018-12-14
浏览次数:908
公司地址:上海市漕宝路66号20F
![]()
刘小姐(女士)
中文名称:溶菌酶肉汤基础规格
英文名称: Lysozyme Broth ba
产品规格: 250g
产品用途: 用于蜡样芽孢杆菌的溶菌酶试验

用于蜡样芽孢杆菌的溶菌酶试验
成分(g/L)
牛肉浸粉 3.0
蛋白胨 5.0
pH值6.8 ± 0.1 25℃
用法
称取本品 8.0g,加热溶解于 1000ml 蒸馏水中,分装于烧瓶中,每瓶 99ml,121℃高压灭菌 15 分钟,冷至50℃左右时,每瓶中加入0.1% 溶菌酶溶液 1ml,混匀后分装无菌试管,每管 2.5ml, 备用。
注:溶菌酶溶液制备:在 65ml 灭菌的 0.1mol/L盐酸中加入 0.1g 溶菌酶,煮沸 20 分钟溶解后,再用灭菌 0.1mol/L 盐酸稀释至 100ml。
溶菌酶肉汤基础规格的特点:
(1)MS培养基 它是1962年由Murashige和Skoog为培养烟草细胞而设计的。特点是无机盐和离子浓度较高,为较稳定的平衡溶液。其养分的数量和比例较合适,可满足植物的营养和生理需要。它的硝酸盐含量较其他培养基为高,广泛地用于植物的器官、花药、细胞和原生质体培养,效果良好。有些培养基是由它演变而来的。
(2)B5培养基 是1968年由Gamborg等为培养大豆根细胞而设计的。其主要特点是含有较低的铵,这可能对不少培养物的生长有抑制作用。从实践得知有些植物在B5培养基上生长更适宜,如双子叶植物特别是木本植物。
(3)White培养基 是1943年由White为培养番茄根尖而设计的。1963年又作了改良,称作White改良培养基,提高了MgSO4的浓度和增加了鹏素。其特点是无机盐数量较低,适于生根培养。
(4)N6培养基 是1974年朱至清等为水稻等禾谷类作物花药培养而设计的。其特点是成分较简单,KNO3和(NH4)2SO4含量高。在已广泛应用于小麦、水稻及其他植物的花药培养和其他组织培养。
(5)KM-80培养基 它是1974年为原生质体培养而设计的。其特点是有机成分较复杂,它包括了所有的单糖和维生素,广泛用于原生质融合的培养。
溶菌酶肉汤基础规格实验内容:
1.称量→溶化→调pH→过滤→分装→加塞→包扎→灭菌→无菌检查
2.干热灭菌:装入待灭菌物品→升温→恒温→降温→开箱取物
3.高压蒸汽灭菌:加水→装物品→加盖→加热→排冷空气→加压→恒压→降压回零→排汽→取物→无菌检查
4.过滤除菌:组装灭菌→连接→压滤→无菌检查→清洗灭菌
溶菌酶肉汤基础规格保存条件:
培养基由于配制的原料不同,使用要求不同,而贮存保管方面也稍有不同。一般培养基在受热、吸潮后,易被细菌污染或分解变质,因此一般培养基必须防潮、避光、阴凉处保存。对一些需严格灭菌的培养基(如组织培养基),较长时间的贮存,必须放在2~6℃的冰箱内。由于液体培养基不易长期保管,现在均改制成粉末。
2-氯-4,6-二苯基-1,3,5-三嗪 3842-55-5
2-溴咔唑 3652-90-2
喹啉-4-硼酸 371764-64-6
喹啉-6-硼酸 376581-24-7
喹啉-7-硼酸 629644-82-2
4-异喹啉硼酸 192182-56-2
7-异喹啉硼酸频哪醇酯 1092790-21-0
1,2,3,4-四氢喹啉-2-羧酸 123811-82-5
1,2,3,4-TETRAHYDRO-QUINOLINE-2-CARBOXYLIC ACID METHYL ESTER 63430-79-5
1,2,3,4-四氢喹啉-2-羧酸乙酯 4620-34-2
4-二苯并呋喃硼酸 100124-06-9
4'-氯联苯-4-硼酸 364044-44-0
N-苯基-3-咔唑硼酸 854952-58-2
(3,5-二苯基苯)硼酸 128388-54-5
4-(1-萘基)苯硼酸 870774-25-7
4-(萘-2-)苯硼酸 918655-03-5
1-溴-3,5二苯基苯 103068-20-8
(10-苯基蒽-9-基)硼酸 334658-75-2
2-溴-9,10-双(2-萘基)蒽 474688-76-1
9-溴-10-(2-萘基)蒽 474688-73-8
9,9'-联蒽 1055-23-8
N,N'-二苯基联苯二胺 531-91-9
N,N'-二(1-萘基)-4,4'-联苯二胺 152670-41-2
N,N'-二对甲苯基联苯胺 10311-61-2
二(4-溴苯基)胺 16292-17-4
NBPHEN 1174006-43-9
3,3'-[5'-[3-(3-吡啶基)苯基][1,1':3',1''-三联苯]-3,3''-二基]二吡啶 921205-03-0
4,4',4''-三(咔唑-9-基)三苯胺 139092-78-7
4,4'-二(9-咔唑)联苯 58328-31-7
26DCZPPY 1013405-24-7
26DCZPPY 1013405-24-7
Coro
Coro
Coro
Coro
15,16-Epoxy-12-hydroxylabda- 8(17),13(16),14-triene
12-Hydroxy-8(17),13-labdadien-16,15-olide
Isocoro
8(17),13-Labdadien-15,16-olide
Villosin
Yunnancoro
3-Epikato
9(11),12-Oleanadien-3-ol
Triptohypol F
溶菌酶肉汤基础规格12-Ursene-3,16,22-triol
5,7-Dihydroxychromone
Oroxylia A
(+)-Taxifolin
Cnidioside B methyl ester
Decarine
9-O-Feruloyllariciresinol
5-(3-Hydroxypropyl)-7-methoxybenzofuran
5-Hydroxymethyl-7-methoxybenzofuran
Isotachioside
Kaerophyllin
Prenylpiperitol
Savinin
Xanthotol
Butane diacid
2-Methoxystypandrone
Torachrysone
Torachrysone 8-O-glucoside
Resveratrol
 免责声明:以上所展示的[ 溶菌酶肉汤基础规格]信息由会员[上海研生实业有限公司]自行提供,内容的真实性、准确性和合法性由发布会员负责。
免责声明:以上所展示的[ 溶菌酶肉汤基础规格]信息由会员[上海研生实业有限公司]自行提供,内容的真实性、准确性和合法性由发布会员负责。